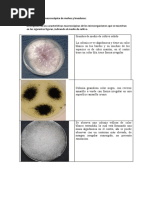

LEON CASAS RENATO
III CICLO B
FAC. CC. BIOLÓGICAS
TEORIA: TAREA 02
Instructivo: Elabora y completa la tabla con las características generales de los diferentes grupos de hongos que existen en la
naturaleza.
Características Generales Hongos: clases Observaciones
Chitridiomicetos Zigomicetos Ascomicetos Basidiomicetos Deuteromicetos
Estructuras y Pared celular Mayormente de -Dura y gruesa de -Dura y gruesa Dura y gruesa Quitina - glucano
composición quitina, algunos quitina o compuesta por compuesta por
de celulosa y en quitosano. Quitina. quitina.
otros no está
presente.
Membrana - Doble capa - Predomina el - Predomina el - Predomina el - Predomina el
celular lipídica ergosterol en vez ergosterol en vez ergosterol en vez ergosterol en vez
-Tiene más grosor del colesterol. del colesterol del colesterol. del colesterol.
-Delgada -Delgada -Delgada -Delgada
Vacuolas de No presentes No presentes en Presentes Presentes Presentes
reserva células pequeñas,
pero si en adultas.
Incluir otras - Algunas - Unicelulares y - Unicelulares y - Pluricelulares - Unicelulares y
importancias especies son pluricelulares. pluricelulares. - Hifas pluricelulares.
unicelulares. - Hifas cenocíticas - Talófitos con compactadas y - Hifas septadas,
- Talo cenocítico y hifas septadas. septadas, multinucleadas y
esferoidal, hifa talos bien - Degradan dicariontes ramificadas.
simple alargada o desarrollados. lignina y (homo o hetero). - El filo de mayor
micelio. - Organización celulosa. - Poseen un patogenicidad
- Células móviles micelial sin cuerpo fructifero humana.
(zoosporas con tabiques o septos (basidiocarpo).
flagelos).
- Algunos son
patógenos
Saprofítica o Saprofíticos, Saprofíticos o Aunque la Saprófitos
Nutrición parásitos de simbiontes parásitos de mayoría son oportunistas.
plantas acuáticas, (mutualistas) o animales, plantas saprófitos, hay Algunas especies
insectos y parásitos de y humanos. simbiontes pueden ser
hongos. plantas, insectos o También (líquenes en parásitas de
HETERÓTROFA pequeños simbiontes pinos) y plantas o de
animales del (líquenes, parásitos. animales, incluido
suelo. micorrizas y el hombre.
mamíferos).
Saprófitos y Saprófitos, Saprófitos, Saprófitos, Saprófitos
Metabolismo parásitos. simbiontes y simbiontes y simbiontes y oportunistas y
� LEON CASAS RENATO
III CICLO B
FAC. CC. BIOLÓGICAS
parásitos. parásitos. parásitos. parásitos.
Sexual: zoosporas Sexual: Sexual: -Sexual: esporas Sexual:
que se forman por zigosporas. ascosporas. endógenas, desconocida.
la fusión de 2 Asexual: Asexual: como Asexual:
Reproducción gametangios. esporangiosporas conidios. basidiosporas. conidios.
Asexual: -Asexual:
zoosporas. esporas
exógenas, como
conidios. (poco
común)
En su mayoría Marinos, agua Ambientes Terrestres y Variado,
acuáticos (agua dulce, terrestres. terrestres, acuáticos. mayormente en
dulce), también Encontrándose acuáticos, Manglares, suelos, aunque
hay terrestres y también en la madera, materia desiertos, pueden estar en
Hábitad algunos parásitos basura, estiércol orgánica en ambientes fríos. ambientes
en las plantas o de animales, descomposición. acuáticos e
insectos. materia orgánica incluso el aire.
en
descomposición.
pH 2,5 – 7,5 2,5 – 7,5 1,4 – 5,8 2,5 – 7,5 2,5 – 7,5
Actividad de Agua libre Agua libre con Agua libre Agua libre Agua libre,
Condiciones de agua Aw: > 0,85 iones. proveniente de proveniente de mucosidades.
crecimiento Aw: > 0,85 lluvias. lluvias. Aw: 0,75 – 0,85
Aw: 0,75 – 0,85 Aw: 0,75 – 0,85
Temperatura 20 a 26 °C 23 a 26 °C 18ºC a 28ºC 18ºC a 30ºC 25ºC a 30ºC
-Batrachochytrium -Rhizopus -Saccharomyces - Botrytis cinérea -Penicillium
dendrobatidis nigricans cerevisiae - Psilocybe -Epidermophyton
Género y/o especies -Synchitrium - Taphrina -Candida cubensis floccosum
representativas endobioticum deformans albicans - Amanita - Tolypocladium
-Coelomyces - Claviceps - Pneumocystis muscaria inflatum
purpurea carinii
Referencias Montoya VH. 2008. Microbiología básica para el área de la salud y afines. 2a edición. Salud - Editorial Universidad de Antioquía,
bibliográficas Colombia.
Deacon JW. 1993. Introducción a la Micología Moderna. Limusa - Noriega Editores, México
ENLACES [Link]
[Link]